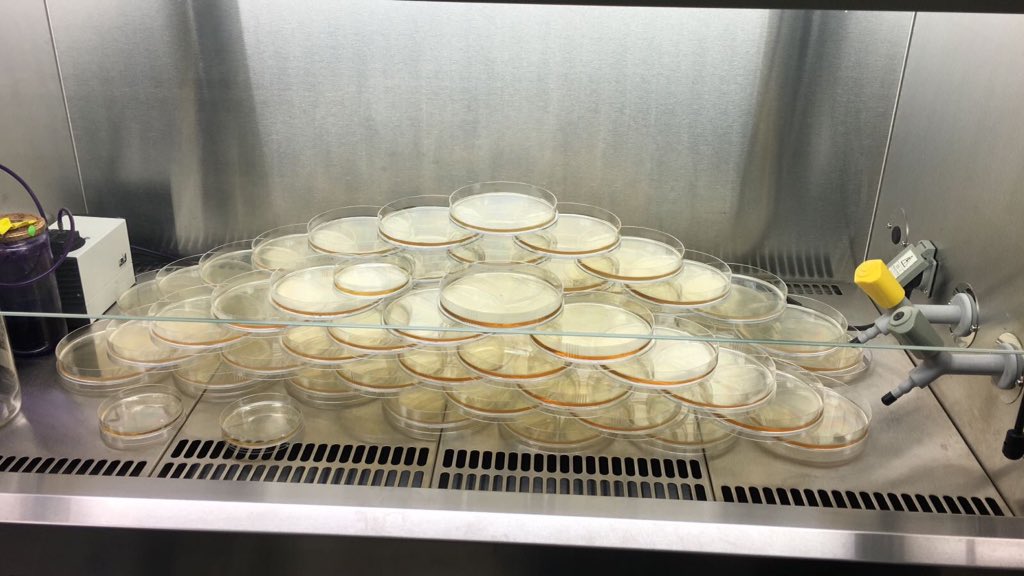
SWI@Spain de <a href="/IDIVALdecilla/">IDIVAL</a> <a href="/IDIVALdireccion/">IDIVAL Direccion</a> en el colegio Esclavas de SANTANDER. Mucha suerte con la caza de #bacterias #AntimicrobialResistance #science #youngscientists #superbugs #cienciaciudadana #Antibióticos #microbiology #microbiologiaambiental

Marcos Lopez Hoyos
@marcoslopezhoy2
ID: 701151598576324608
20-02-2016 21:09:02
833 Tweet
218 Followers
74 Following


#CongresoSET18 | En el área de los #trasplantes, el principal reto de la regeneración celular reside en crear en el laboratorio tejidos funcionales donde se reproduzca la arquitectura y riqueza de los tejidos naturales cc SETrasplante ow.ly/mDU330kMco2


Los avances del tto inmunosupresor ha aumentado el pool de receptores de un 2nd/3rd trasplante altamente sensibilizados...como valoramos los Ab contra el epitopo HLA DP? #TTS2018 S.E.N. Nefrología SETrasplante Beatriz Fernandez Fernandez Asun Sancho x.com/julikanter/sta…


Kiran Khush, profesora de Stanford University y directora del Registro Internacional de #Trasplante Cardíaco, declaró en una reunión en el Hospital #chuac que pese al avance en corazón artificial, el trasplante sigue siendo la mejor opción bit.ly/2tEEWUC La Voz de Galicia












Consulta aquí ➡ bit.ly/2DTS37u los ponentes confirmados para el 5º Congreso de la SETrasplante

![SETrasplante (@setrasplante) on Twitter photo [INTERESANTE] El #trasplante de pulmón es una cirugía para remover un pulmón enfermo y reemplazarlo por uno sano. +Info: bit.ly/2HRzCXR @nih_nhlbi [INTERESANTE] El #trasplante de pulmón es una cirugía para remover un pulmón enfermo y reemplazarlo por uno sano. +Info: bit.ly/2HRzCXR @nih_nhlbi](https://pbs.twimg.com/media/Dcqe2POWAAAOWPL.jpg)